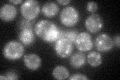
YDL099W
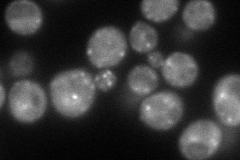
YDL099W
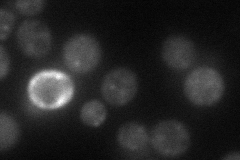
YDL099W
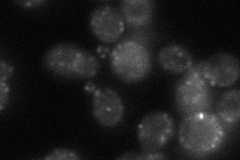
YDL099W
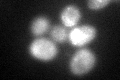
YDL099W
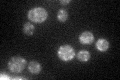
YDL099W

View description
Cis-golgi localized protein involved in ER to Golgi transport; forms a complex with the mammalian GRASP65 homolog, Grh1p; mutants are compromised for the fusion of ER-derived vesicles with Golgi membranes
Localization:
Intensity:
Fold change:
Significance:
-
C’ GFP library in SD
punctate44.65 -
N' NOP1pr-GFP in SD
punctate95.4718 -
N' TEF2pr-mCherry in SD
punctate39.0176 -
N' NATIVEpr-GFP in SD
punctate44.2337 -
N' TEF2pr-VC and Cyto-VN in SD

below threshold36.3536 -
C’ GFP library in SD+DTT
punctate54.831.22No -
C’ GFP library in SD+H2O2

punctate45.51.01No -
C’ GFP library in Starvation Media
punctate51.81.15No -
C’ GFP library on the background of Pup2-DaMP

punctate -
C’ GFP library on the background of CCT mutant

punctate49.39461.10598No
